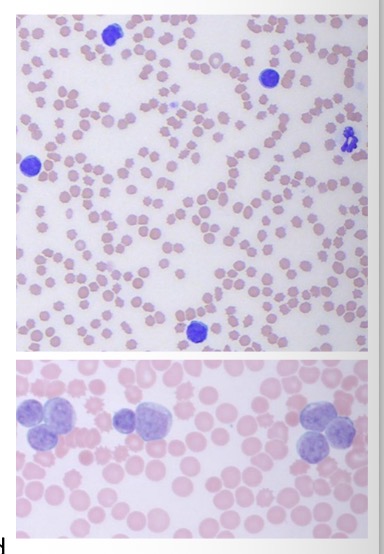
<p>Haematopoietic neoplasia def</p>

leukocyte responses in disease
1/58
There's no tags or description
Looks like no tags are added yet.
Name | Mastery | Learn | Test | Matching | Spaced |
|---|
No study sessions yet.
59 Terms
What stimulates leukocyte production/release
Infl cytokines
Leukocyte types in innate immunity → phagocytosis
Neutrophils, monocytes
Leukocyte types in adaptive immunity
Lymphocytes
Leukocyte types in parasite defence immunity + allergies
Eosinophils, basophils
Granulocyte/polymorphonuclear leukocytes (cytoplasmic granules + lobulated nu)
Neutrophil, eosinophil, basophils
Agranuloytes / mononuclear leukocytes
Lymphocytes, monocytes

Normal leukocyte morphology - a
Neutrophil


Normal leukocyte morphology - B
Lymphocyte


Normal leukocyte morphology - C
Eosinophil


Normal leukocyte morphology - D
Monocyte


Normal leukocyte morphology - E
Basophil


Leukocytosis def
Inc WBC count


Leukopenia def
Dec WBC count

Leukocyte kinetics + pools - precursors for leukocytes
Bone marrow, lymphoid tissue
Leukocyte kinetics + pools - What happens to granulocytes
Die
Leukocyte kinetics + pools - What happens to lymphocytes
Return to blood via lymph or die
Leukocyte kinetics + pools - What happens to monocytes
Transform into macrophages / dendritic cells then die

Neutrophil life cycle
Mature in bone marrow 5-7d
Short half life in blood
Migrate to tissues for function
Die or lost across mucosal surface


Left shift meaning
Hallmark of acute/active infl
Immature neutrophil release as storage dec
Band neutrophil (non segmented nu)

Features of regenerative left shift
Segmented neutrophils > immature neutrophils
Features of degenerative left shift
Immature neutrophils > segmented neutrophils
What is Pelger-Huët and how does it affect WBC analysis
Hyposegmented granulocyte hereditary disorder
→ appears like band neutrophils in left shift (infl)

Toxic changes to neutrophils
Foamy cytoplasm
Diffuse cytoplasmic basophilia
Döhle Bodies
Asynchronous nu maturation
Giant neutrophils
Toxic granules
Defects from accelerated neutropoiesis

Aetiology of Neutrophilia
Infl (infl Neutrophilia)
Excess catecholamines (physiologic Neutrophilia)
Excess glucocorticoids (stress Neutrophilia)
Chronic myeloid leukaemia
Paraneoplastic syndrome
Aetiology of Neutrophilia- infl Neutrophilia/ lymphopenia/ monocytosis causes + features
Inf, immune mediated disease, neoplasia, necrosis
Left shift if acute infl
Often not if CNS, superficial skin, lower urinary tract
Aetiology of Neutrophilia- stress Neutrophilia/lymphopenia/ monocytosis causes + features
Excess glucocorticoids
Inc neutrophils from bone marrow
With lymphopenia, monocytosis, eosinopenia
Stress leukogram features
Neutrophilia, lymphopenia, monocytosis, eosinopenia
Lymphocytosis/ eosinophilia due to hypoadrenocorticism results in (leukogram)
Neutropenia, Lymphocytosis, monopenia, eosinocytosis
Aetiology of Neutrophilia- physiologic Neutrophilia causes + features
Excess catecholamines
Transient
With Lymphocytosis, monocytosis
Aetiology of neutropenia
Inc use
Dec/ineffective production
Endotoxaemia
Immune mediated neutropenia
Haemophagocytic syndrome
Cyclic haematopoiesis (collies, FeLV)
Aetiology of neutropenia- inc use causes + features
Acute infl (When migration to inflamed tissue exceeds release from bone marrow), bacterial infections
Left shift
Aetiology of neutropenia- inadequate production causes + features
Bone marrow disorder, infection (parvo, FeLV, ehrlichia), drug toxicity (oestrogen, chemo), myelofibrosis, myelophthisis
Persistent without left shift
Lymphocytes - where are they made
Produced in bone marrow, primary lymphoid tissue
T cells mature in thymus
B + NK cells mature in bone marrow + lymphoid tissues

Types of lymphocyte
Small, intermediate, large, reactive, granular

Aetiology of Lymphocytosis
Chronic infl/antigenic stimulation
Excess catecholamines (physiologic)
Lymphoproliferative disease
Hypoadrenocorticism
Young
Aetiology of Lymphocytosis - chronic infl/antigenic stimulation features
Reactive lymphocytes, Neutrophilia, monocytosis, eosinophilia
Aetiology of Lymphocytosis - physiologic Lymphocytosis associated with
Physiologic Neutrophilia, granular lymphocytes
Aetiology of Lymphocytosis - types of lymphoproliferative disease leading to inc lymphocyte count
Neoplastic disease, chronic lymphocytic leukaemia, leukaemic phase of lymphoma
Aetiology of Lymphopenia
Excess glucocorticoids (stress)
Acute infl
Depletion (loss of fluid → enteric disease, chylothorax drainage)
Hypoplasia / destruction/ disruption of lymphoid tissue T cells- multicentric lymphoma, immunosuppressive drugs

Monocyte cytoplasm appearance
Lightly Basophilic/ amphorphilic
Vacuoles

Monocytes kinetics
Produced in bone marrow
1-3d half life in blood
Macrophages + dendritic cells longer half life
Monocytosis aetiology
Infl (acute, chronic)
Excess glucocorticoids
Secondary to neutropenia
Chronic myeloid leukaemia
Monocytosis aetiology - why is it secondary to neutropenia
Share common bipotential stem cell

What is most suggestive of acute infl
Neutrophilia + left shift

Leukocyte abnormalities in stressed dog
Neutrophilia, lymphopenia, monocytosis, eosinopenia, left shift

What is true regarding neutrophils
Infl can cause Neutrophilia

Eosinophils kinetics
Produced in bone marrow
Short blood half life
Long half life in tissues
Eosinophilia aetiology
Hypersensitivity reactions - fleas bite dermatitis, feline asthma, food
Parasitism
Infl - idiopathic (eosinophilic enteritis, eosinophilic bronchopneumonia, eosinophilic panosteritis)
Neoplasia - chronic eosinophilic leukaemia / paraneoplastic
Hypereosinophilic syndrome
Hypoadrenocorticism
Basophils kinetics
Produced in bone marrow
2-3 d half life in blood
Short tissue half life
Mast cells kinetics
Produced in bone marrow
In blood as undifferentiated cells
In tissues as long lived cells

Mast cells appearance
Large, round nu, purple cytoplasmic granules, not seen in health


Mast cells vs basophils
M- round nu, larger
B- lobulated nu

Aetiology of basophilia
With eosinophilia
Hypersensitivity
Parasitism
Neoplasia
Mastocytosis defined as
1+ mast cell in blood smear
Mastocytosis aetiology
Mast cell tumour
Acute infl disease
Which conditions are rare
Monocytopenia, eosinopenia, basopenia
Haematopoietic neoplasia def
Clonal proliferation of lymphocytes, leukocytes + their precursors (lymphoid + myeloid origin)

Haematopoietic neoplasia Features
Marked leukocytosis
Haematopoietic neoplasia Types
Acute leukaemia - poorly differentiated
Chronic - well differentiated
Leukaemic phase of lymphoma - infiltrating blood